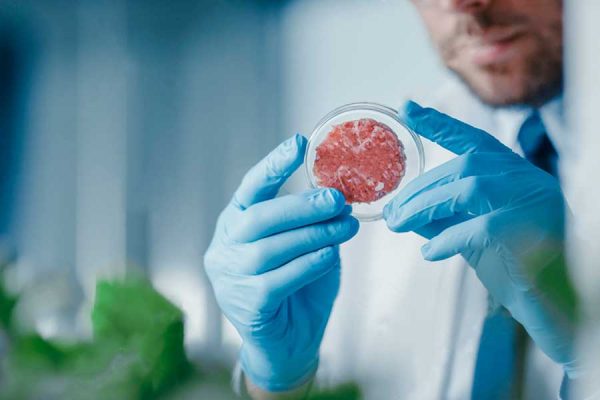

Los antibióticos ya no están funcionando ¿cómo puedo ayudar para que el problema no avance?
El mal uso que les hemos dado a estos medicamentos durante décadas ha provocado que las bacterias hayan desarrollado resistencia. ¿Cómo podemos contribuir a que el problema no avance?